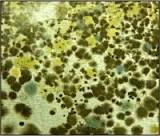

hepa air purifier mould

Mold / Toxic Mold Allergies Along with pollens from trees, grasses, and weeds, molds are a leading cause of seasonal allergic rhinitis. In warm regions, molds may be present year round. In colder areas, the mold season generally runs from early spring until well into the fall, typically peaking during July and August. While most molds, like pollens, are killed by the first major frost, others may persist during the winter months, even in cold regions. There are literally thousands of types of mold. The seeds or reproductive particles of fungi are known as spores. It is usually these spores that actually cause mold allergies. A single mold growth can spawn literally millions of spores. Molds can be found wherever moisture and oxygen are present. Rotting logs and vegetation are prime habitat for molds, as are damp walls and carpet. Some molds attach to certain grasses, weeds, and grains such as wheat, oats, barley, and corn. Molds thrive at room temperature making them troublesome inside the home, where they can often be found in damp basements and closets (in sheetrock, wallboard, and insulation), bathrooms, refrigerators, house plants, air conditioning systems, humidifiers, foam pillows, washing machines, dryer vents, and furniture.

Certain workplace environments are also very prone to mold infestation problems. Mold allergies are caused by inhaled mold spores, or inhaled fragments of mold growths. Fortunately, while there are thousands of types of molds, only a few dozen are believed to cause severe allergies. Symptoms of mold allergy are similar to other allergies, including nasal congestion, sneezing, watery and itching eyes, dry tickling throat, recurrent ear infections, rashes, coughing, sore throat, post nasal drip, and breathing difficulties. In some individuals, exposure to certain molds can lead to asthma or to a rare lung disease called allergic bronchopulmonary aspergillosis which is characterized by wheezing, low-grade fever, and coughing-up brown-flecked masses or mucus plugs. In fact, some research suggests that exposure to mold allergens could be an underlying cause of many undiagnosed ailments that manifest in symptoms of chronic fatigue, sinus and respiratory problems, and recurrent throat infections.

Black (toxic) mold, called Stachybotys, is a particular threat.
ozone ionizer cleaner ionic air purifierIt is especially toxic and can prove to be a serious health threat, particularly to children with mold allergies.
abc air duct cleaning orlandoStachybotys is widespread in the southern U.S. were foam board insulation was used without adequate ventilation.
totaline air purifierSymptoms of an allergic toxic mold reaction are generally the same as traditional mold allergies, however, they are usually much more severe and could progress to: coughing up blood, nose bleeds, anemia, memory loss, pulmonary hemorrhage, and even coma or death. The good news is that, similar to pollen allergens, mold spores can be effectively removed from the air with a good quality HEPA air filter.

The Austin Air and Airpura air cleaners use medical-grade HEPA filters which are very effective at removing mold allergens and in relieving the symptoms of mold allergies. In fact, symptomatic relief can occur within 24-48 hours of installing a HEPA filter. As with any filter targeting particulate, select a model with a large HEPA filter for best performance and long filter life. For more information on the Austin Air and Airpura air cleaner models: In addition to using a medical-grade HEPA air filter to remove airborne mold spores, you can do the following to reduce your exposure to potentially harmful molds: Mold infestation often occurs after a home is flooded due to heavy rain, river overflow, or internal plumbing failure. To prevent hidden mold infestation inside walls, etc., professional flood restoration contractors are recommended when these events occur. Massive mold colonies quickly grew in homes in the aftermath of Hurricane Katrina in New Orleans and was responsible for significant illness.

For more information on specific other allergens, click on the links below:A few days ago, I wrote an article about the dangers of mold, and the response I received was overwhelming. Everybody wanted to know more about mold. In fact, within a few days of publishing the post, I got a couple dozen emails asking how to get rid of mold. So, I wanted to share my personal tips that I use at my home, as well as here in the office. Please feel free to drop your tips in the comment section below. How to Get Rid of Mold: Investigate your home or office for moisture leakage. If you find any moisture leaks, clean them up with a dry towel immediately and find the source of the leak. Consider hiring a professional if the leak does not stop or if you are dealing with a plumbing issue. Controlling moisture leaks in your home or place of work will reduce the mold’s ability to thrive. Mold loves warm and wet places. If you live in a place with humidity levels of 70% or more, you must particularly take heed to prevent toxic moldy air.
Invest in a high-quality dehumidifier and test your home for mold over-growth. Temperatures above 75° F, as well as poorly lit rooms and unmoving air, can actually create more mold. Keep fresh air moving in your home, as well as bright sunlight coming in through your windows. This will help reduce toxic mold. Open a window while you take a shower, if possible. Change air filters regularly in heating and air-conditioning vents. Invest in a good quality air purification system that employs both a HEPA filter and UV & negative ion technologies. In my opinion, this will give you the best results when cleaning your air. Keep your home at a moderate temperature, at around 69-73° F and keep the humidity level at 54% and below. Make sure your clothes dryer has an anti-humidity vent. Check closets for mold growth. This is especially important if you have ever placed wet or damp clothing in your closets. If you find mold in your closet, wash your clothes immediately to help clean any possible mold spores.

Protect your breathing passages when removing active or dead mold. Wear a mask, eye protection and protective gloves that filter mold. When cleaning, slightly wet the mold to lessen the amount of airborne spores in the breathing atmosphere while you are cleaning. This can be done with a wet cloth. Scrub hard surfaces infested in mold with a non-ammonia soap. Non-toxic, organic soap is best for the environment. Porous surface cannot be cleaned of mold. Things like moldy carpeting, drywall, wall-paper, fabric, or other porous surfaces, must be completely removed and replaced from your home or office. If you have mold on the structural support of your home or office building, it may not be cleaned out by scrubbing alone. It may have to be sanded. Don’t forget to wear the appropriate protective coverings. Remember, the best prevention for mold is to KEEP THINGS DRY and always use a good air purification system! Do you know of any other ways to get rid of mold?